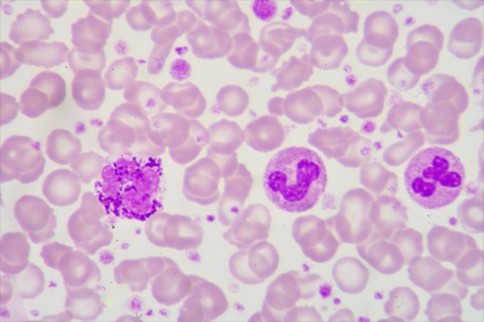
研究人員發(fā)現(xiàn)分子內(nèi)部的兩個元素對于其作為腫瘤抑制因子的功能比其他元素更重要

全球服務熱線:400-086-8008
腫瘤出國看病:研究發(fā)現(xiàn)MEG3親吻環(huán)可抑制腫瘤生長
【本文為疾病百科知識,僅供閱讀】 2019-08-23 作者:厚樸方舟
較近一項發(fā)表在Molecular Cell上研究稱,EMBL Grenoble的Marcia小組的一組研究人員發(fā)現(xiàn)腫瘤抑制因子MEG3采用復雜的三維結構來實現(xiàn)其功能。此外,他們能夠通過有針對性地操縱這種架構來微調(diào)其活動。該研究可能有助于推進某類癌癥的診斷和治療。

和其他許多生物體一樣,人體細胞已經(jīng)開發(fā)出保護自身免受癌癥侵害的機制。健康細胞產(chǎn)生一系列分子,阻止有害突變積累。我們基因組中較著名的監(jiān)護人是蛋白質(zhì)p53:每當p53失活或發(fā)生功能障礙時,患癌癥的風險就會大大增加。
MEG3由Marco Marcia及其EMBL Grenoble小組詳細研究,是我們細胞產(chǎn)生的另一種預防癌癥的分子。它的功能來自刺激p53。然而,與p53不同,MEG3不是一種蛋白質(zhì),屬于過去20年內(nèi)發(fā)現(xiàn)的一類RNA分子,稱為長非編碼RNA(lncRNAs簡稱)。而人體細胞可能含有比蛋白質(zhì)更多的lncRNA,這些RNA的生物學重要性和作用機制仍然很難模糊。
一些lncRNA,如MEG3,與疾病有關,但科學家們無法破譯它們的確切運作方式。這引起了該領域一些研究人員的懷疑,Marcia說:“由于缺乏對lncRNA如何發(fā)揮作用的分子理解,許多科學家仍質(zhì)疑這些分子的實際功能相關性?!?/p>
Marcia的目標是通過研究lncRNA的三維形狀來改變這種看法。研究團隊希望了解更多關于lncRNA結構將有助于理解這些分子如何發(fā)揮作用。“三維結構提供分子圖譜,生物分子的分子制圖。當一個人來到一個新的城市時,人們想知道火車站在哪里,市政廳,學校,公園在哪里,因為那些是使生物分子正常運轉(zhuǎn)的城市元素。生物分子也是如此:你想知道它們是如何折疊和結構化的,這樣你才能識別出它們的功能單元,“瑪西婭說。
利用生物化學,細胞生物學和單粒子原子力顯微鏡,該團隊非常詳細地研究了MEG3的結構。該小組系統(tǒng)地刪除并修改了MEG3的構建模塊,以找出其中哪些對于其功能至關重要。這樣,研究人員發(fā)現(xiàn)分子內(nèi)部的兩個元素對于其作為腫瘤抑制因子的功能比其他元素更重要。
MEG3在不同的哺乳動物組織中是豐富的,特別是腦和腦垂體中的內(nèi)分泌腺。當MEG3不能正常工作時,大腦和垂體中的腫瘤會發(fā)展。迄今為止,這些類型的腫瘤只能通過手術治療。克服侵入性手術需求的一種方法是刺激腫瘤中的MEG3活性。設計穩(wěn)定MEG3親吻環(huán)的藥物可以改善其腫瘤抑制功能,使其能夠阻止腫瘤生長。關于健康MEG3的組成的知識也可能有助于識別具有異常折疊的MEG3的患有癌癥風險較高的人。
厚樸方舟2012年進入海外醫(yī)療領域,總部位于北京,建立了由全球權威醫(yī)學專家組成的美日名醫(yī)集團,初個擁有日本政府官方頒發(fā)的海外醫(yī)療資格的企業(yè)。如果您有海外就醫(yī)的需要,請撥打免費熱線400-086-8008進行咨詢!
本文由厚樸方舟編譯,版權歸厚樸方舟所有,轉(zhuǎn)載或引用本網(wǎng)版權所有之內(nèi)容須注明"轉(zhuǎn)自厚樸方舟官網(wǎng)(m.wyaoyao.cn)"字樣,對不遵守本聲明或其他違法、惡意使用本網(wǎng)內(nèi)容者,本網(wǎng)保留追究其法律責任的權利。
上一篇:出國看?。红o脈補充維生素治療方法到底是什么?有沒有用? 下一篇:出國看?。貉芯堪l(fā)現(xiàn)哮喘患者支氣管痙攣原因,有望為治療支氣管痙攣提供新策略
熱門服務
推薦閱讀
日本權威醫(yī)學專家
日本醫(yī)院排名
服務案例更多>
全球咨詢服務熱線
400-086-8008
English | 微信端

互聯(lián)網(wǎng)藥品信息服務資格證書編號:(京)·非經(jīng)營性·2015·0179
厚樸方舟健康管理(北京)有限公司 版權所有 m.wyaoyao.cn
京ICP備15061794號
京公網(wǎng)安備 11010502027115號